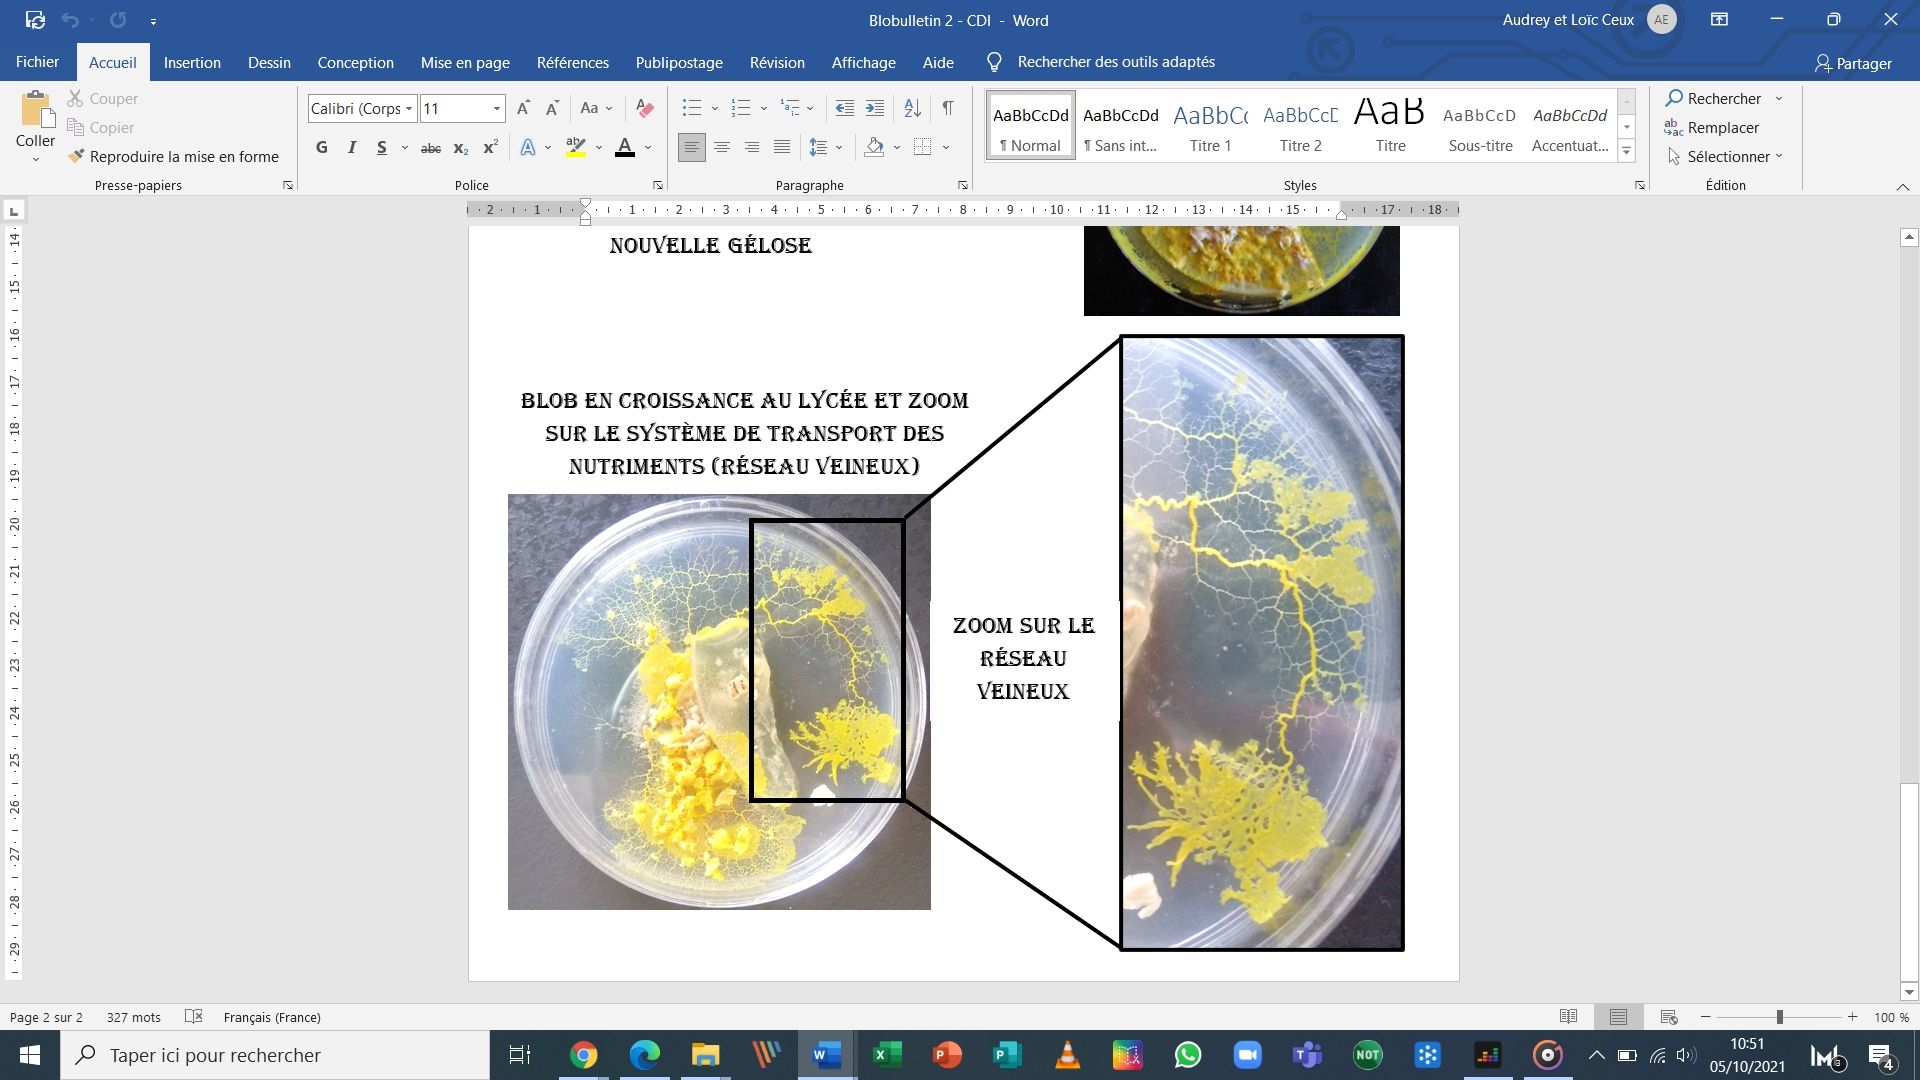

Préparation des expériences sur le Blob et des outils de communication avec les autres classes
Le blob est en croissance depuis un mois au lycée. Il s’est bien multiplié ce qui nous a permis de produire de nombreux sclérotes (Blobs déshydratés) qui seront nécessaires pour la réalisation des expériences identiques à Thomas Pesquet dans la station spatiale internationale (ISS).
Les expériences seront mises en œuvre la semaine du 11 octobre par les 4500 établissements sélectionnés pour le projet : #elevetonblob.
Les élèves de 207 travaillent sur le projet depuis 1 mois. Ils sont en train de produire des affiches de présentation du blob et des expériences à réaliser. Ils ont imaginé également une affiche relatant comment le blob a inspiré la culture (films, musique, littérature, séries…). Vous pourrez retrouver ce travail au CDI dès la semaine prochaine.
Ils ont aussi conçu des capsules audios afin de demander de l’aide à des élèves de SI (Sciences de l’ingénieur) et de spécialité de physique-chimie :
Bon courage à eux ! A suivre…
Ils ont aussi conçu des capsules audios afin de demander de l’aide à des élèves de SI (Sciences de l’ingénieur) et de spécialité de physique-chimie :
- Les élèves de SI vont produire des blobox identiques à celle de l’ISS dans laquelle les blobs seront réveillés. Ils vont également concevoir des labyrinthes pour tester l’intelligence du Blob. Arrivera-t’il à trouver la sortie et sa nourriture ?
- Les élèves de Spécialité physique-chimie ont pour mission de nous aider à identifier et caractériser les pigments jaunes du Blob.
Bon courage à eux ! A suivre…

Image 1

Image 1 X

Image 2

Image 3
Image 3 X

X
Des articles à consulter ...
Menu matières
Recherche
-

Préparation des expériences sur le Blob et des outils de communication avec les autres classes










